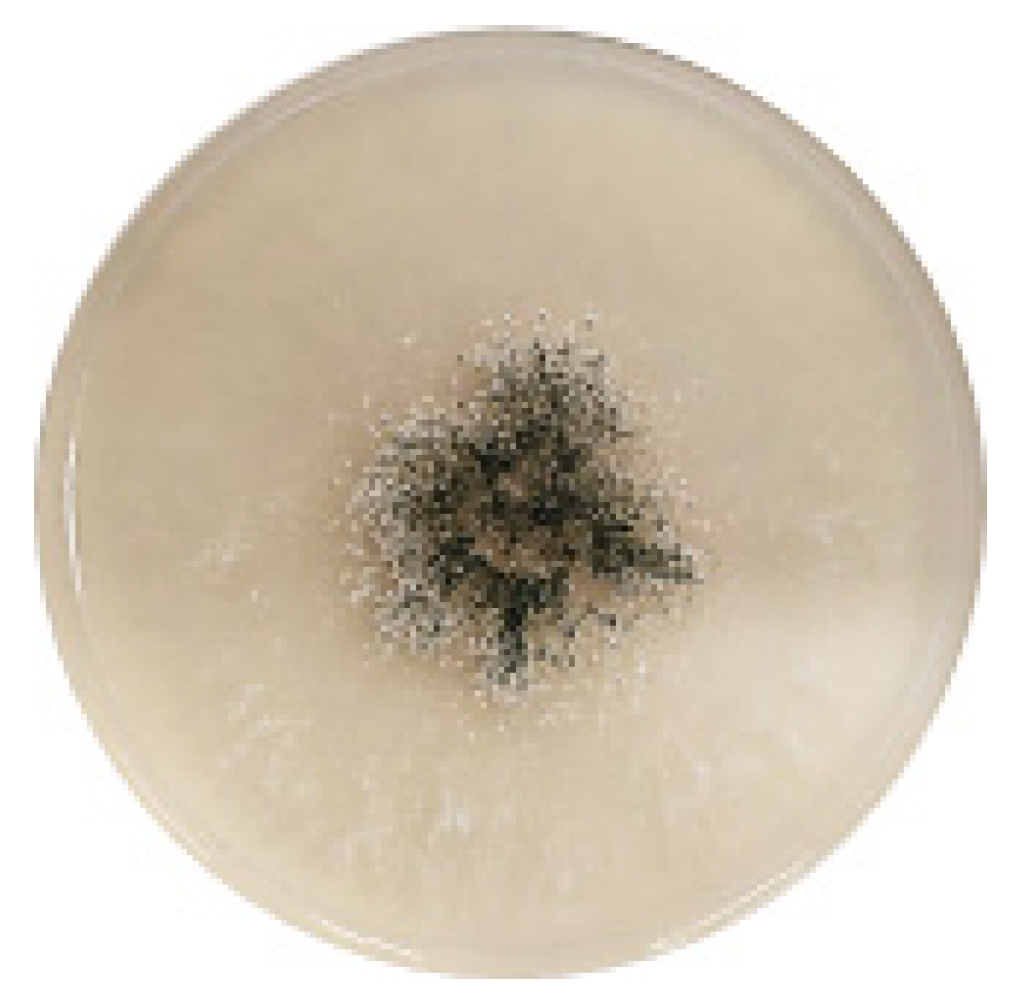
Sustainability 15 00168 g001 Sustainability 15 00168 g001

From Waste Biomass to Cellulosic Ethanol by Separate Hydrolysis and Fermentation (SHF) with Trichoderma viride
Abstract
1. Introduction
2. Materials and Methods
2.1. Feedstock for Ethanol Fermentation
2.2. Biological Biomass Pretreatment
2.3. Production of Cellulase—Index Activity
2.4. Experimental Procedure of SHF Method
2.5. Statistical Analysis
3. Results and Discussion
3.1. Susceptibility of Lignocellulosic Biomass to Biological Pretreatment
3.2. Cellulolytic Activity of Trichoderma Viride
3.3. Separate Hydrolysis and Fermentation
4. Conclusions
Author Contributions
Funding
Institutional Review Board Statement
Informed Consent Statement
Data Availability Statement
Conflicts of Interest
References
- Lee, R.A.; Lavoie, J.-M. From first- to third-generation biofuels: Challenges of producing a commodity from a biomass of increasing complexity. Anim. Front. 2013, 3, 6–11. [Google Scholar] [CrossRef]
- Baudry, G.; Delrue, F.; Legrand, J.; Pruvost, J.; Vallée, T. The challenge of measuring biofuel sustainability: A stakeholder-driven approach applied to the French case. Renew. Sustain. Energy Rev. 2017, 69, 933–947. [Google Scholar] [CrossRef]
- Heo, S.; Choi, J. Potential and environmental impacts of liquid biofuel from agricultural residues in Thailand. Sustainability 2019, 11, 1502. [Google Scholar] [CrossRef]
- Jeswani, H.K.; Chilvers, A.; Azapagic, A. Environmental Sustainability of Biofuels: A Review. Proc. R. Soc. A 2020, 476, 20200351. [Google Scholar] [CrossRef] [PubMed]
- Shahare, V.V.; Kumar, B.; Singh, P. Biofuels for sustainable development: A global perspective. In Green Technologies and Environmental Sustainability; Singh, R., Kumar, S., Eds.; Springer: Berlin/Heidelberg, Germany, 2017; pp. 67–89. [Google Scholar] [CrossRef]
- Singh, D.P.; Trivedi, R.K. Biofuel from wastes an economic and environmentally feasible resource. Energy Procedia 2014, 54, 634–641. [Google Scholar] [CrossRef][Green Version]
- Putro, J.N.; Soetaredjo, F.E.; Lin, S.Y.; Ju, Y.H.; Ismadi, S. Pretreatment and conversion of lignocellulose biomass into valuable chemicals. RSC Adv. 2016, 6, 46834–46852. [Google Scholar] [CrossRef]
- Hasanov, I.; Raud, M.; Kikas, T. The Role of Ionic Liquids in the Lignin Separation from Lignocellulosic Biomass. Energies 2020, 13, 4864. [Google Scholar] [CrossRef]
- Aftab, M.N.; Iqbal, I.; Riaz, F.; Karadag, A.; Tabatabaei, M. Different Pretreatment Methods of Lignocellulosic Biomass for Use in Biofuel Production In Biomass for Bioenergy-Recent Trends and Future Challenges; Abomohra, A.E.-F., Ed.; IntechOpen: London, UK, 2019. [Google Scholar] [CrossRef]
- Sanchez, C. Lignocellulosic residues: Biodegradation and bioconversion by fungi. Biotechnol. Adv. 2009, 27, 185–194. [Google Scholar] [CrossRef]
- Tsegaye, B.; Balomajumder, C.; Roy, P. Microbial delignification and hydrolysis of lignocellulosic biomass to enhance biofuel production: An overview and future prospect. Bull. Natl. Res. Cent. 2019, 43, 51. [Google Scholar] [CrossRef]
- Neethu, K.; Rubeena, M.; Sajith, S.; Sreedevi, S.; Priji, P.; Unni, K.N.; Sarath Josh, M.K.; Jisha, V.N.; Pradeep, S.; Benjamin, S. A novel strain of Trichoderma viride shows complete lignocellulolytic activities. Adv. Biosci. Biotechnol. 2012, 3, 1160–1166. [Google Scholar] [CrossRef]
- Rubeena, M.; Neethu, K.; Sajith, S.; Sreedevi, S.; Priji, P.; Unni, K.N.; Sarath Josh, M.K.; Jisha, V.N.; Pradeep, S.; Benjamin, S. Lignocellulolytic activities of a novel strain of Trichoderma harzianum. Adv. Biosci. Biotechnol. 2013, 4, 214–221. [Google Scholar] [CrossRef]
- Wagner, A.; Lackner, N.; Mutschlechner, M.; Prem, E.; Markt, R.; Illmer, P. Biological pretreatment strategies for second-generation lignocellulosic resources to enhance biogas production. Energies 2018, 11, 1797. [Google Scholar] [CrossRef]
- Hu, J.; Arantes, V.; Saddler, J.N. The enhancement of enzymatic hydrolysis of lignocellulosic substrates by the addition of accessory enzymes such as xylanase: Is it an additive or synergistic effect? Biotechnol. Biofuels 2011, 4, 36. [Google Scholar] [CrossRef]
- Yang, B.; Dai, Z.; Ding, S.Y.; Wyman, C.E. Enzymatic hydrolysis of cellulosic biomass. Biofuels 2011, 2, 421–449. [Google Scholar] [CrossRef]
- Bhaumik, P.; Dhepe, P.L. Conversion of biomass into sugars. In Biomass Sugars for Non-Fuel Applications; Murzin, D., Simakova, O., Eds.; Royal Society of Chemistry: London, UK, 2015; pp. 1–53. [Google Scholar]
- Loow, Y.-L.; Wu, T.Y.; Jahim, J.M.; Mohammad, A.W.; Teoh, W.H. Typical conversion of lignocellulosic biomass into reducing sugars using dilute acid hydrolysis or alkaline pretreatment. Cellulose 2016, 23, 1491–1520. [Google Scholar] [CrossRef]
- Hawrot-Paw, M.; Koniuszy, A.; Zając, G.; Szyszlak-Bargłowicz, J.; Jaklewicz, J. Production of 2nd generation bioethanol from straw during simultaneous microbial saccharification and fermentation. Arch. Environ. Prot. 2020, 46, 47–52. [Google Scholar]
- Sindhu, R.; Binod, P.; Pandey, A. Biological pretreatment of lignocellulosic biomass–An overview. Bioresour. Technol. 2016, 199, 76–82. [Google Scholar] [CrossRef]
- Dahnum, D.; Tasum, S.O.; Triwahyuni, E.; Nurdin, M.; Abimanyu, H. Comparison of SHF and SSF processes using enzyme and dry yeast for optimization of bioethanol production from empty fruit bunch. Energy Procedia 2015, 68, 107–116. [Google Scholar] [CrossRef]
- Erdei, B.; Franko, B.; Galbe, M.; Zacchi, G. Separate hydrolysis and co-fermentation for improved xylose utilization in integrated ethanol production from wheat meal and wheat straw. Biotechnol. Biofuels 2012, 5, 12. [Google Scholar] [CrossRef]
- Qin, L.; Zhao, X.; Li, W.-C.; Zhu, J.-Q.; Liu, L.; Li, B.-Z.; Yuan, Y.-J. Process analysis and optimization of simultaneous saccharification and co-fermentation of ethylenediamine-pretreated corn stover for ethanol production. Biotechnol. Biofuels 2018, 11, 118. [Google Scholar] [CrossRef]
- Olguin-Maciel, E.; Singh, A.; Chable-Villacis, R.; Tapia-Tussell, R.; Ruiz, H.A. Consolidated Bioprocessing, an Innovative Strategy towards Sustainability for Biofuels Production from Crop Residues: An Overview. Agronomy 2020, 10, 1834. [Google Scholar] [CrossRef]
- Binood, P.; Sindhu, R.; Pandey, A. The Alcohol Fermentation Step: The Most Common Ethanologenic Microorganisms Among Yeasts, Bacteria and Filamentous Fungi. In Lignocellulose Conversion; Faraco, V., Ed.; Springer: Berlin/Heidelberg, Germany, 2013. [Google Scholar] [CrossRef]
- Bušić, A.; Mardetko, N.; Kundas, S.; Morzak, G.; Belskaya, H.; Šantek, M.I.; Komes, D.; Novak, S.; Šantek, B. Bioethanol production from renewable raw materials and its separation and purification: A review. Food Technol. Biotechnol. 2018, 56, 289–311. [Google Scholar] [CrossRef] [PubMed]
- Kumar, S.; Singh, N.; Prasad, R. Anhydrous ethanol: A renewable source of energy. Renew. Sustain. Energy Rev. 2010, 14, 1830–1844. [Google Scholar] [CrossRef]
- Ferdes, M.; Dinca, M.N.; Moiceanu, G.; Zabava, B.S.; Paraschiv, G. Microorganisms and Enzymes Used in the Biological Pretreatment of the Substrate to Enhance Biogas Production: A Review. Sustainability 2020, 12, 7205. [Google Scholar] [CrossRef]
- Anwar, Z.; Gulfraz, M.; Irshad, M. Agro-industrial lignocellulosic biomass a key to unlock the future bioenergy: A brief review. J. Rad. Res. Appl. Sci. 2014, 7, 163–173. [Google Scholar] [CrossRef]
- Li, Y.; Khanal, S.K. Bioenergy: Principles and Applications; Wiley Blackwell: Hoboken, NJ, USA, 2017. [Google Scholar]
- Ahorsu, R.; Medina, F.; Constantí, M. Significance and Challenges of Biomass as a Suitable Feedstock for Bioenergy and Biochemical Production: A Review. Energies 2018, 11, 3366. [Google Scholar] [CrossRef]
- Fiserova, M.; Opalena, E.; Illa, A. Comparative study of hemicelluloses extraction from beech and oak wood. Wood Res. 2013, 58, 543–554. [Google Scholar]
- Maeda, R.N.; Serpa, V.I.; Rocha, V.A.L.; Mesquita, R.A.A.; Santa Anna, L.M.M.; Machado de Castro, A.; Driemeier, C.E.; Pereira Jr., N.; Polikarpov, I. Enzymatic hydrolysis of pretreated sugar cane bagasse using Penicillium funiculosum and Trichoderma harzianum cellulases. Process Biochem. 2011, 46, 1196–1201. [Google Scholar] [CrossRef]
- Vermaas, J.V.; Petridis, L.; Qi, X.; Schulz, R.; Lindner, B.; Smith, J.C. Mechanism of lignin inhibition of enzymatic biomass deconstruction. Biotechnol. Biofuels 2015, 8, 217. [Google Scholar] [CrossRef]
- Singhvi, M.; Kim, B.S. Green hydrogen production through consolidated bioprocessing of lignocellulosic biomass using nanobiotechnology approach. Bioresour. Technol. 2022, 365, 128108. [Google Scholar] [CrossRef]
- Wi, S.G.; Cho, E.J.; Lee, D.-S.; Lee, S.J.; Lee, Y.J.; Bae, H.-J. Lignocellulose conversion for biofuel: A new pretreatment greatly improves downstream biocatalytic hydrolysis of various lignocellulosic materials. Biotechnol. Biofuels 2015, 8, 228. [Google Scholar] [CrossRef]
- Su, Y.; Yu, X.; Sun, Y.; Wang, G.; Chen, H.; Chen, G. Evaluation of Screened Lignin-degrading Fungi for the Biological Pretreatment of Corn Stover. Sci. Rep. 2018, 8, 5385. [Google Scholar] [CrossRef]
- Bari, E.; Taghiyari, H.R.; Naji, H.R.; Schmidt, O.; Ohno, K.M.; Clausen, C.A.; Bakar, E.S. Assessing the destructive behaviors of two white-rot fungi on beech wood. Int. Biodeterior. Biodegrad. 2016, 114, 129–140. [Google Scholar] [CrossRef]
- Ghorbani, F.; Karimi, M.; Biria, D.; Kariminia, H.R.; Jeihanipour, A. Enhancement of fungal delignification of rice straw by Trichoderma viride sp. to improve its saccharification. Biochem. Eng. J. 2015, 101, 77–84. [Google Scholar] [CrossRef]
- Ladeira Ázar, R.I.S.; Bordignon-Junior, S.E.; Laufer, C.; Specht, J.; Ferrier, D.; Kim, D. Effect of Lignin Content on Cellulolytic Saccharification of Liquid Hot Water Pretreated Sugarcane Bagasse. Molecules 2020, 25, 623. [Google Scholar] [CrossRef]
- Saini, J.K.; Saini, R.; Tewari, L. Lignocellulosic agriculture wastes as biomass feedstocks for second-generation bioethanol production: Concepts and recent developments. 3 Biotech 2015, 5, 337–353. [Google Scholar] [CrossRef]
- Pinheiro, T.; Coelho, E.; Romaní, A.; Domingues, L. Intensifying ethanol production from brewer’s spent grain waste: Use of whole slurry at high solid loadings. New Biotechnol. 2019, 53, 1–8. [Google Scholar] [CrossRef]
- Mishra, P.K.; Gregor, T.; Wimmer, R. Utilising brewer’s spent grain as a source of cellulose nanofibres following separation of protein-based biomass. BioResources 2017, 12, 107–116. [Google Scholar] [CrossRef]
- Bhattacharya, S.; Das, A.; Patnaik, A.; Bokade, P.; Rajan, S.S. Submerged fermentation and characterization of carboxymethyl cellulase from a rhizospheric isolate of Trichoderma viride associated with Azadirachta indica. J. Sci. Ind. Res. 2014, 73, 225–230. [Google Scholar]
- Hawrot-Paw, M.; Izwikow, M. Cellulolytic activity of Trichoderma viride with regard to selected lignocellulosic waste materials. J. Ecol. Eng. 2016, 17, 119–122. [Google Scholar] [CrossRef][Green Version]
- Malik, S.K.; Mukhtar, H.; Farooqi, A.A.; Haq, I. Optimization of process parameters for the biosynthesis of cellulases by Trichoderma viride. Pak. J. Bot. 2010, 42, 243–4251. [Google Scholar]
- Mithra, M.G.; Jeeva, M.L.; Sajeev, M.S.; Padmaja, G. Comparison of ethanol yield from pretreated lignocellulo-starch biomass under fed-batch SHF or SSF modes. Heliyon 2018, 4, e00885. [Google Scholar] [CrossRef] [PubMed]
- Mendez, J.; de França Passos, D.; Wischral, D.; Modesto, L.F.; Pereira Jr, N. Second-generation ethanol production by separate hydrolysis and fermentation from sugarcane bagasse with cellulose hydrolysis using a customized enzyme cocktail. Biofuels 2021, 12, 1225–1231. [Google Scholar] [CrossRef]
- Kim, S.; Dale, B.E. Global potential bioethanol production from wasted crops and crop residues. Biomass Bioenerg. 2004, 26, 361–375. [Google Scholar] [CrossRef]
- Yasin, M. Performance evaluation of mobile straw baler. J. Agric. Res. 2012, 50, 261–270. [Google Scholar]
- Phuong, D.V.; Quoc, L.P.T.; Tan, P.V.; Duy, L.N.D. Production of bioethanol from Robusta coffee pulp (Coffea robusta L.) in Vietnam. Foods Raw Mater. 2019, 7, 10–17. [Google Scholar] [CrossRef]
- Lara-Serrano, M.; Angulo, F.S.; Negro, M.J.; Morales-delaRosa, S.; Campos-Martín, J.M.; Fierro, J.L. Second-Generation Bioethanol Production Combining Simultaneous Fermentation and Saccharification of IL-Pretreated Barley Straw. ACS Sustain. Chem. Eng. 2018, 6, 7086–7095. [Google Scholar] [CrossRef]
- Cutzu, R.; Bardi, L. Production of bioethanol from agricultural wastes using residual thermal energy of a cogeneration plant in the distillation phase. Fermentation 2017, 3, 24. [Google Scholar] [CrossRef]
- Xian, X.; Fang, L.; Zhou, Y.; Li, B.; Zheng, X.; Liu, Y.; Lin, X. Integrated Bioprocess for Cellulosic Ethanol Production from Wheat Straw: New Ternary Deep-Eutectic-Solvent Pretreatment, Enzymatic Saccharification, and Fermentation. Fermentation 2022, 8, 371. [Google Scholar] [CrossRef]
- Saka, A.; Afolabi, A.S. Production and characterization of bioethanol from sugarcane bagasse as alternative energy sources. In Proceedings of the World Congress on Engineering, London, UK, 1–3 July 2015; pp. 876–880. [Google Scholar]
- Tomás-Pejó, E.; Fermoso, J.; Herrador, E.; Hernando, H.; Jiménez-Sánchez, S.; Ballesteros, M.; González-Fernández, C.; Serrano, D.P. Valorization of steam-exploded wheat straw through a biorefinery approach: Bioethanol and bio-oil co-production. Fuel 2017, 199, 403–412. [Google Scholar] [CrossRef]
- Boonchuay, P.; Techapun, C.; Leksawasdi, N.; Seesuriyachan, P.; Hanmoungjai, P.; Watanabe, M.; Takenaka, S.; Chaiyaso, T. An integrated process for xylooligosaccharide and bioethanol production from corncob. Bioresour. Technol. 2018, 256, 399–407. [Google Scholar] [CrossRef]
- Unrean, P.; Ketsub, N. Integrated lignocellulosic bioprocess for co-production of ethanol and xylitol from sugarcane bagasse. Ind. Crops Prod. 2018, 123, 238–246. [Google Scholar] [CrossRef]
- Irfan, M.; Nadeem, M.; Syed, Q. Ethanol production from agricultural wastes using Sacchromyces cervisae. Braz. J. Microbiol. 2014, 45, 457–465. [Google Scholar] [CrossRef]
- López-Linares, J.C.; Romero, I.; Cara, C.; Ruiz, E.; Moya, M.; Castro, E. Bioethanol production from rapeseed straw at high solids loading with different process configurations. Fuel 2014, 122, 112–118. [Google Scholar] [CrossRef]
- Saini, R.; Chen, C.-W.; Patel, A.K.; Saini, J.K.; Dong, C.-D.; Singhania, R.R. Valorization of Pineapple Leaves Waste for the Production of Bioethanol. Bioengineering 2022, 9, 557. [Google Scholar] [CrossRef]
- Dodo, C.M.; Mamphweli, S.; Okoh, O. Bioethanol production from lignocellulosic sugarcane leaves and tops. J. Energy S. Afr. 2017, 28, 1–11. [Google Scholar] [CrossRef]
- Paschos, T.; Louloudi, A.; Papayannakos, N.; Kekos, D.; Mamma, D. Potential of barley straw for high titer bioethanol production applying pre-hydrolysis and simultaneous saccharification and fermentation at high solid loading. Biofuels 2020, 13, 467–473. [Google Scholar] [CrossRef]
- Zhang, J.; Chu, D.; Huang, J.; Yu, Z.; Dai, G.; Bao, J. Simultaneous saccharification and ethanol fermentation at high corn stover solids loading in a helical stirring bioreactor. Biotechnol. Bioeng. 2010, 105, 718–728. [Google Scholar] [CrossRef]
- Tiwari, S.; Jadhav, S.K.; Tiwari, K.L. Bioethanol production from rice bran with optimization of parameters by Bacillus cereus strain McR-3. Int. J. Environ. Sci. Technol. 2015, 12, 3819–3826. [Google Scholar] [CrossRef]
- da Silva, F.L.; de Oliveira Campos, A.; dos Santos, D.A.; Batista Magalhães, E.R.; de Macedo, G.R.; dos Santos, E.S. Valorization of an agroextractive residue—Carnauba straw—For the production of bioethanol by simultaneous saccharification and fermentation (SSF). Renew. Energy 2018, 127, 661–669. [Google Scholar] [CrossRef]
- Takano, M.; Hoshino, K. Bioethanol production from rice straw by simultaneous saccharification and fermentation with statistical optimized cellulase cocktail and fermenting fungus. Bioresour. Bioprocess. 2018, 5, 16. [Google Scholar] [CrossRef]
- Waghmare, P.R.; Khandare, R.V.; Jeon, B.; Govindwar, S.P. Enzymatic hydrolysis of biologically pretreated sorghum husk for bioethanol production. Biofuel Res. J. 2018, 5, 846–853. [Google Scholar] [CrossRef]

| Index Activity (IA) | Temperature | ||
| 25 °C | 30 °C | 35 °C | |
| 1.31 | 1.33 | 1.25 | |
| 1.25 | 1.20 | 1.18 | |
| 1.38 | 1.23 | 1.38 | |
| Mean ± SD | 1.31 ± 0.7 | 1.25 ± 0.7 | 1.27 ± 0.10 |
| Lignocellulosic Biomass | Pretreatment | Ethanol Yield | References |
|---|---|---|---|
| barley straw | biological | 65% (v/v) | present study |
| barley straw | ionic liquids | 18.5 g/L | Lara-Serrano et al. [52] |
| maize residues | - | 10.22% (v/v) | Cutzu and Bardi [53] |
| wheat straw | deep eutectic solvent (des) | 15.42 g/L | Xian et al. [54] |
| sugar cane pulp | dilute acid | 15.5% | Saka and Afolabi [55] |
| wheat straw | steam explosion | 21.3 g/L | Tomás-Pejó et al. [56] |
| corncob | alkaline | 32.32 g/L | Boonchuay et al. [57] |
| sugarcane bagasse | acid | 56.1 g/L | Unrean and Ketsub [58] |
| sugarcane bagasse | mixed H2O2 + NaOH | 66 g/L | Irfan et al. [59] |
| rapeseed straw | acid | 39.9 g/L | López-Linares et al. [60] |
| pineapple leaves waste | hydrothermal | 9 g/L | Saini et al. [61] |
| sugarcane leaves and tops | combination of oxidative alkali–peroxide | 13.7 g/L | Dodo et al. [62] |
Disclaimer/Publisher’s Note: The statements, opinions and data contained in all publications are solely those of the individual author(s) and contributor(s) and not of MDPI and/or the editor(s). MDPI and/or the editor(s) disclaim responsibility for any injury to people or property resulting from any ideas, methods, instructions or products referred to in the content. |
© 2022 by the authors. Licensee MDPI, Basel, Switzerland. This article is an open access article distributed under the terms and conditions of the Creative Commons Attribution (CC BY) license (https://creativecommons.org/licenses/by/4.0/).
Share and Cite
Hawrot-Paw, M.; Stańczuk, A. From Waste Biomass to Cellulosic Ethanol by Separate Hydrolysis and Fermentation (SHF) with Trichoderma viride. Sustainability 2023, 15, 168. https://doi.org/10.3390/su15010168
Hawrot-Paw M, Stańczuk A. From Waste Biomass to Cellulosic Ethanol by Separate Hydrolysis and Fermentation (SHF) with Trichoderma viride. Sustainability. 2023; 15(1):168. https://doi.org/10.3390/su15010168
Chicago/Turabian StyleHawrot-Paw, Małgorzata, and Aleksander Stańczuk. 2023. "From Waste Biomass to Cellulosic Ethanol by Separate Hydrolysis and Fermentation (SHF) with Trichoderma viride" Sustainability 15, no. 1: 168. https://doi.org/10.3390/su15010168
APA StyleHawrot-Paw, M., & Stańczuk, A. (2023). From Waste Biomass to Cellulosic Ethanol by Separate Hydrolysis and Fermentation (SHF) with Trichoderma viride. Sustainability, 15(1), 168. https://doi.org/10.3390/su15010168

